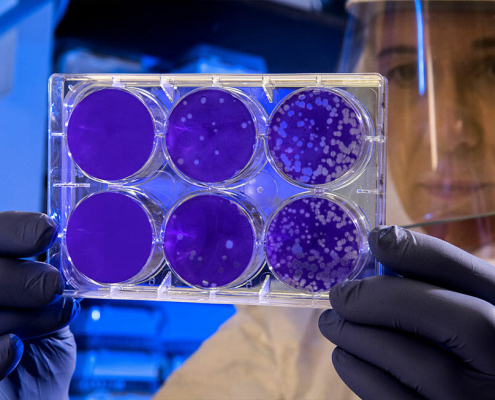
coronavirus and pets

Puppy Scams Increase over COVID-19
According to the Crime and Corruption Committee, almost a million…

The Most Unusual Claims
Pet Insurance Australia has released its top unusual pet claims…

Top 20 Dog Breeds – 2020
Pet insurance Australia is proud to announce the top 20 dog breeds…

Free Webinars for Pet Parents & Vets
Pet Insurance Australia is proud to announce the PetSure Paws…

Time to Give a Big THANK YOU
Pet Insurance Australia is reminding all pet owners to help give…

COVID-19 Support Australian Owned
In light of the current economic crisis, Pet Insurance Australia…

Fostering Pets Can Help
Considering adopting or fostering a pet? Now is the perfect time…
Coronavirus & Pets
With the current outbreak of COVID-19 or Coronavirus, many pet…

Why Get Pet Insurance?
Considering pet insurance? Pet Insurance Australia investigates…

7 Step Checklist on Pre-Pet Insurance with Pet Insurance Australia
Considering pet insurance? Pet Insurance Australia takes a look…
